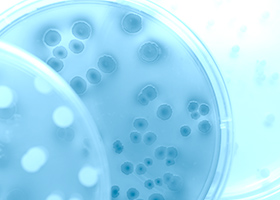
幹細胞培養

膝の痛み Knee Pain
自家脂肪由来幹細胞を用いた関節治療 Joint Treatment Using Stem Cells
「⾃分の(⾃家)」・「脂肪から取り出した(脂肪由来)」・「幹細胞」を用いるので、細胞には「⾃家脂肪由来幹細胞」という名前がついています。
モティーフ銀座クリニックで提供している幹細胞治療は、あなたの体からほんの数グラムの脂肪を採取し、そこから幹細胞を取り出して増殖培養させ、あなたの膝に移植します。
移植された幹細胞が軟骨を再生し、それと一緒に炎症を抑えます。この一連の流れによって膝の痛みを減少させることができると考えられています。
次のお悩みはありませんか?

次のお悩みはありませんか?
- 痛みを減少させたい
- 重症化したくない
- 鎮痛剤やヒアルロン酸注射が効かない
- 入院したくない
- 手術は受けたくない
- 冬の寒さや夏の冷房で膝が冷えると痛い
これらのお悩みにモティーフ銀座クリニックの幹細胞治療はお役に立てるかもしれません。
変形性膝関節症
膝の痛みや可動域の制限でお悩みの方の多くが、変形性膝関節症と診断されています。これは、膝関節内の軟骨が摩耗し、関節の骨が変形してしまう疾患です。初期~中期の患者様には、痛み止めの飲み薬や湿布、さらにはヒアルロン酸注射などの保存療法が一般的に用いられています。これらの治療法は、運動療法などと組み合わせることで一時的な痛みの緩和が見込まれますが、根本的な治療には至りません。時間が経つにつれて軟骨の摩耗は進行し、症状が悪化することが多いのです。
進行期に達した場合、膝の変形や痛みが強くなり、最終的には人工関節置換術が必要となることもあります。人工関節手術は有効な治療法ではありますが、手術への不安やリスク、リハビリテーションの必要性などから、手術を避けたいと考える方も多くいらっしゃいます。
幹細胞治療:保存療法と手術の間に位置する新たな選択肢
これまで、保存療法と手術の中間に位置する治療はほとんど存在しませんでした。しかし、近年注目されているのが幹細胞治療です。モティーフ銀座クリニックでは、脂肪由来間葉系幹細胞(AD-MSCs)を用いた治療を提供しています。この治療は、膝関節症の進行を抑制し、軟骨の再生をサポートする新しいアプローチです。


モティーフ銀座クリニックの幹細胞治療とは?
当クリニックでは、患者様ご自身の皮下脂肪からほんの数グラムを採取し、そこから幹細胞を抽出して増殖・培養します。培養された高品質な幹細胞は、膝関節に移植され、軟骨の修復や再生を促進するとともに、関節内の炎症を抑える効果が期待されています。
軟骨再生の促進
幹細胞は、損傷した軟骨に作用し、新しい軟骨細胞の形成をサポートします。これにより、膝の可動域の改善や、関節機能の向上が期待できます。
炎症の軽減
幹細胞から分泌される成長因子や抗炎症因子は、膝関節内の炎症を抑制し、痛みの軽減に寄与します。この作用により、炎症性サイトカインの活動を抑え、関節内の組織損傷を防ぐことができます。
これにより、膝の痛みを軽減し、症状の進行を抑えることが可能となります。幹細胞治療は、従来の保存療法に限界を感じている方や、手術を避けたい方に新たな選択肢を提供します。
リハビリテーションの重要性
幹細胞治療の効果を最大限に引き出すためには、適切なリハビリテーションが重要です。モティーフ銀座クリニックでは、治療後の患者様に適したリハビリテーション計画を提供しています。膝関節の運動機能を改善し、治療効果を持続させるためには、医師の指導に基づいたリハビリテーションが欠かせません。自己流のリハビリは、幹細胞治療の効果を損なうリスクがあるため、専門家の指導を受けながら治療を進めていくことが推奨されます
幹細胞治療の流れ
当クリニックでは、幹細胞治療を開始する前に、患者様の膝の状態を正確に把握するためにレントゲン写真やMRI画像を使用して詳細な診察を行います。もし必要であれば、信頼できるMRI検査施設をご紹介いたします。
治療は複数回の施術が必要になることもあり、長期的な視点で少しずつ治療を進めることが重要です。患者様ごとの治療計画に基づき、最適なタイミングで治療を行いながら、痛みの軽減と膝機能の改善を目指していきます。

① 初診
⾃覚症状を問診で伺い、他覚症状を診察にて発⾒し、⾃⼰幹細胞治療が適切かどうかの判断を⾏います。過去の既往歴や常備薬をお知らせください。
事前にMRI撮影が必要なことが多いので、かかりつけ医からの画像をお持ちいただくか、必要に応じて提携のクリニックでMRI撮影の予約を致します。MRI撮影費用は治療費とは別にかかります(保険適応可)。
医師とよく相談して納得された上で治療を受けてください。

② 細胞採取
⼿術室または処置室で局所⿇酔使⽤して、0.5~3g程度の⽪下脂肪を採取します。場合により⽪膚縫合します。基本的に抜⽷は不要です。
ご希望により静脈⿇酔を使⽤します。所要時間は10分程度です。
感染症などのために⾎液検査を⾏います。
③ 幹細胞培養
モティーフ銀座クリニック併設の細胞培養室で幹細胞を培養(2週間~4週間)します。
⾎液検査で⼤幅に異常値が出て緊急を要する場合には、クリニックからご連絡いたします。
また、幹細胞治療よりも先に治療を⾏わなければならない場合には、そちらを優先していただきます。

④ 幹細胞投与
培養した幹細胞を患部に投与致します。
所要時間はおよそ5分程度です。

⑤ 再診
治療後の経過について、診察致します。
変形性膝関節症の新しい希望として
変形性膝関節症において、従来の治療法では対応しきれない症状や、手術を避けたいと考える方にとって、幹細胞治療は新しい希望となる治療法です。モティーフ銀座クリニックでは、患者様ご自身の幹細胞を用いた治療を提供し、膝の痛みを軽減し、関節の機能を向上させるサポートを行っています。診察時には、患者様に最適な治療計画を丁寧にご説明いたしますので、ぜひご相談ください。
幹細胞治療は厚生労働省に第二種再生医療等提供計画を提出し、受理されなければできません。
モティーフ銀座クリニックは論文等の根拠を記載した提供計画を提出・受理されております。
また、細胞培養施設の届出も済ませており、細胞採取から投与まで一度も院外へ出すことなく、一貫して治療を提供できます。
■ 細胞加工施設届出番号 FC3230138
リスク
リスクとしては脂肪採取部の痛み・しびれ・出⾎・傷跡、注⼊部の痛み、注⼊した関節部の違和感・疼痛・発⾚・感染があります。
適切な方法で行った場合、これまで重⼤な副作⽤の報告はありません。
医療費控除について
医療費控除とは、1年間(1月1日〜12月31日までの間)に10万円以上の医療費を支払った場合に受けられる控除です。
確定申告が必要になりますので、当院で発行する領収書を大切に保管しておいてください(領収書の再発行はできません)。
医療費控除や確定申告について不明な点がありましたら、お近くの税務署までお問い合わせください。
担当医師について

担当医師について
モティーフ銀座クリニックには、これまでに大手美容外科クリニックの院長を歴任してきた医師が在籍しています。再生医療の症例も数多く経験し、培った技術で患者様の悩みを解決いたします。







